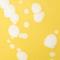
Chamomile

Brighten your kitchen and table with the playful charm of the Rafaela collection. Each hand-applied splash of paint adds a unique, carefree touch to every meal. Available in four bold colors, Rafaela pieces are perfect for mixing and matching or adding a pop of personality to any table setting. From dinner and salad plates to versatile oven-to-table bakers, this collection transforms everyday dining into a vibrant, memorable experience.
Brighten your kitchen and table with the playful charm of the Rafaela collection. Each hand-applied splash of paint adds a unique, carefree touch to every meal. Available in four bold colors, Rafaela pieces are perfect for mixing and matching or adding a pop of personality to any table setting. From dinner and salad plates to versatile oven-to-table bakers, this collection transforms everyday dining into a vibrant, memorable experience.
Brighten your kitchen and table with the playful charm of the Rafaela collection. Each hand-applied splash of paint adds a unique, carefree touch to every meal. Available in four bold colors, Rafaela pieces are perfect for mixing and matching or adding a pop of personality to any table setting. From dinner and salad plates to versatile oven-to-table bakers, this collection transforms everyday dining into a vibrant, memorable experience.